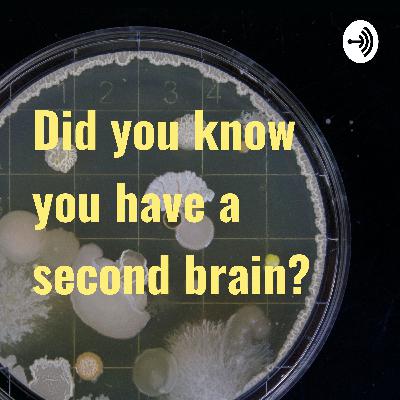

Did you know you have a second brain?
Subscribed: 1Played: 2
Subscribe
© Elli Clark
Description
This podcast explores what the human microbiome and why is it so important for our body. Through the microbiome, our bodies can actually be considered an ecosystem. How interesting is that?!
2 Episodes
Reverse
Comments